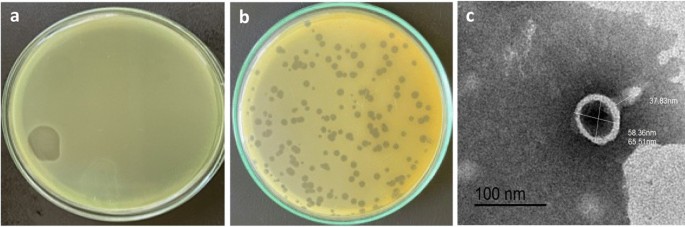

Exploring a New Frontier: Phage Therapy in Canine Pyoderma
The antibiotic resistance dilemma has long been a nerve-racking challenge in both human and veterinary medicine. Recently, however, a novel study has shed light on an alternative strategy that could change the way we manage bacterial infections, especially in our furry friends. In this opinion editorial, we take a closer look at the potential of bacteriophages—viruses that specifically target bacteria—as a promising substitute for conventional antibiotic therapies in treating canine pyoderma. This editorial will dig into the research on Pseudomonas phage HJ01, discussing its characteristics and its potential practical applications while also addressing the tangled issues related to antibiotic misuse and resistance.
In today’s world, with bacterial pathogens evolving and emerging with twisted resistance to standard treatments, the study of phage therapy represents an essential alternative. Pseudomonas aeruginosa, a common culprit behind stubborn skin infections in dogs, has posed a significant challenge due to its high degree of antibiotic resistance. However, a recent investigation into phage HJ01 offers hope for a more targeted, safer, and effective treatment, ultimately benefiting both veterinary practitioners and pet owners.
Pioneering Research in Phage Therapy: A Closer Look at HJ01
Phage HJ01 was isolated from untreated wastewater and has been shown to have a rapid lytic cycle against multidrug-resistant strains of P. aeruginosa. The study detailed its morphological features—such as a capsid diameter of around 55 nm and a tail length nearing 75 nm—as well as its rapid replication, boasting a latent period of approximately 20 minutes and a burst size of 52 plaque-forming units (PFU) per infected cell.
This research highlights several key aspects:
- Rapid Replication: HJ01’s ability to swiftly multiply within the host bacteria makes it particularly effective in quickly reducing bacterial populations.
- Thermal and pH Stability: The phage remains active in a temperature range up to 50 °C and within a pH window of 6.0 to 8.0, which suggests that it can be reliably applied in clinical scenarios involving companion animals.
- Host Specificity: Although primarily targeting P. aeruginosa, HJ01 has shown evidence of lysing other bacterial species such as certain Escherichia coli strains, thereby hinting at a potential multi-target action when used within a phage cocktail.
These findings are not only fascinating but also give us a glimpse into a future where phages may be strategically used to work around the confusing bits and twists and turns of antibiotic resistance.
Addressing the Tangled Issues of Antibiotic Resistance in Companion Animals
Antibiotic resistance has become one of the most intimidating issues in both human and veterinary care. Often, when a pet’s skin infection is treated with multiple courses of antibiotics, the bacteria evolve to become resistant, leaving clinicians with very few effective options. In research focusing on P. aeruginosa, the failure of systemic antibiotic treatments has led veterinarians to look for alternative drugs or methods to alleviate recurring infections.
In canine pyoderma cases, the reliance on traditional antibiotics has sometimes led to:
- Recurrent infections despite rigorous treatment regimens.
- The evolution of multidrug resistance that limits available treatment options.
- Increased risks of zoonotic transmission, ultimately posing problems for pet owners as well.
In light of these challenges, the introduction of phage therapy offers a critical, more focused approach. Unlike broad-spectrum antibiotics that can unintentionally damage the commensal bacteria on the skin and in the gut, phages like HJ01 are highly specific when it comes to their bacterial targets, thereby leaving the surrounding benign microbial population intact.
Understanding the Mechanisms: How Does Phage HJ01 Work?
Phage therapy essentially leverages natural viruses to fight harmful bacteria. Here’s how HJ01 works:
- Adsorption: The phage attaches to specific receptors on the bacterial surface.
- Injection and Replication: Once attached, it injects its genetic material into the bacterial cell, commandeering the host’s systems to reproduce.
- Lysis: After a cycle of replication, the infected cell bursts (lyses), releasing new phage particles that can then infect other bacteria.
This straightforward yet effective mechanism allows phages to continuously reproduce at the site of infection, turning them into self-propagating therapeutic agents. Such a process is especially beneficial when tackling complicated pieces of antibiotic-resistant bacterial strains.
Key Insights from the HJ01 Experiments
The study on phage HJ01 delved into several critical experiments that help outline its potential role in clinical applications. Key insights included the determination of the multiplicity of infection (MOI), one-step growth curves, temperature and pH stability testing, as well as bulletproof evaluations of bacteriolytic activity. These experiments collectively underline why HJ01 could be regarded as a game changer.
| Parameter | Value/Observation | Implication |
|---|---|---|
| Capsid Diameter | ~55 nm | Indicates a small, efficient viral structure |
| Tail Length | ~75 nm | Essential for attaching to bacterial cells |
| Latent Period | ~20 minutes | Shows rapid initiation of bacterial lysis |
| Burst Size | 52 PFU/cell | Reflects effectiveness in producing new phages |
| Optimal pH Range | 6.0 – 8.0 | Ensures stable activity for skin and subcutaneous applications |
| Thermal Stability | Up to 50°C | Useful for febrile patients or warmer climates |
This table helps simplify the fine points of HJ01’s characteristics which are crucial for its potential deployment in real-world settings. When evaluating a new treatment, these measurable indicators provide the little twists that make phage therapy a must-have alternative under specific circumstances.
Overcoming the Off-Putting Reality of Multidrug-Resistant Bacteria
For many pet owners, recurring skin infections are not only physically painful for the animal but also emotionally draining. The nerve-racking struggle with persistent infections is often compounded by the fear of ineffective treatments. In cases where P. aeruginosa is resistant to multiple common antibiotics, the pressure mounts as both clinician and pet owner navigate an overwhelming treatment landscape.
Consider the following points regarding antibiotic-resistant infections in dogs:
- The infection can lead to severe skin damage over time.
- Repeated antibiotic courses contribute to broader patterns of resistance.
- There is a growing risk of transmitting these resistant strains to humans.
Phage therapy, represented by studies like the one focused on HJ01, offers a means to find your way through these troubling issues. Rather than relying on a one-size-fits-all antibiotic that may have off-target effects, phages offer a targeted approach designed to robustly combat specific bacterial invaders while coexisting peacefully with the natural microbiota.
Phage Therapy in the Veterinary Clinic: Practical Considerations
Integrating phage therapy into everyday veterinary practice is not without its tricky parts, but the potential benefits may well outweigh the challenges. Here are a few areas that deserve attention:
Safety and Regulatory Challenges
One of the main concerns in any new therapeutic approach is its safety profile. Fortunately, the genomic analysis of phage HJ01 did not reveal any virulence or antibiotic resistance genes, demonstrating its potential safety for use. However, this is just one step in the process. Veterinary clinics looking to integrate phage therapy must work through numerous regulatory hoops and ensure that the therapeutic preparation is consistently pure and reliable.
Application Methods and Dosage
In the research, subcutaneous injections of HJ01 demonstrated promising results in treating infected dogs. The controlled administration allowed for rapid distribution of the phage to the infected tissues, with treated dogs showing a significant decline in pruritus (itching), reduced inflammatory signs, and accelerated skin repair. While injection is one route, other methods such as topical applications or phage-infused dressings are also being explored. Each application method comes with its own set of nitty-gritty details:
- Subcutaneous injections ensure quick systemic access.
- Topical formulations deliver high concentrations directly to the site of infection.
- Oral forms have been tested but may face challenges due to stomach acidity.
For most cutaneous infections, managing your way through the administration of the phage by injection or local application seems particularly promising. Nonetheless, precise dosage, frequency of administration, and delivery routes still need further exploration in larger-scale trials.
Integration with Existing Therapies
While the idea of completely replacing antibiotics with phage therapy is appealing, many experts now advocate for combining both approaches. Phage therapy can serve as an adjunct to traditional treatments, potentially reducing the dosage and duration of antibiotic use and thereby safeguarding beneficial microbiota. Such a combined approach might help steer through the possible risks associated with both treatments while harnessing the strengths of each.
Benefits for Pet Owners and Veterinary Practitioners
The adoption of phage therapy holds the promise of not only revolutionizing treatment paradigms within veterinary medicine but also easing the emotional and financial burdens faced by pet owners. Consider these promising benefits:
- Targeted Treatment: Thanks to their high specificity, phages can act against only the pathogenic bacteria, leaving the beneficial microbes largely unaffected.
- Reduced Side-Effects: Unlike broad-spectrum antibiotics, phages minimally disrupt the natural microbial environment, reducing the risks of secondary infections.
- Self-Amplification at the Site of Infection: Once administered, phages replicate in situ, potentially reducing the need for repeated dosages.
- Potential for Lower Costs: Over time, as production and preparation methods improve, phage therapy could become a cost-effective alternative to prolonged antibiotic courses.
For veterinary practitioners, the use of phages like HJ01 might mean settling the tangled issues that often complicate treatment plans for recurrent infections. With a therapy that can be fine-tuned based on individual cases, clinicians have a new tool in their therapeutic arsenal that complements and sometimes even replaces standard methods.
Real-World Applications and Future Perspectives
Though still emerging and loaded with its own set of challenges, phage therapy has been gaining attention worldwide. In some parts of Europe and Asia, phage therapy is being actively researched and even applied in pilot studies, particularly within the realm of human medicine. As we observe these trends, there are a few factors that make veterinary applications particularly appealing:
- Animal pathogens, especially those like P. aeruginosa responsible for pyoderma, are often similar in their resistance patterns to those seen in human medicine. By addressing these animal health issues, we may also curb further transmission of multidrug-resistant strains to humans.
- The relative ease of accessing and testing phages from natural sources such as wastewater can speed up the research process, offering pet practitioners new treatment options more quickly than traditional drug development cycles.
- The overall safety profile observed in experimental studies means that, with proper regulatory oversight, phage therapy could be implemented in clinical practice sooner rather than later.
Looking forward, multiple research groups are exploring the potential benefits of phage cocktails—combinations of different phages that together can broaden the host range and reduce the chance of developing phage resistance. The study of HJ01 hints at this possibility by demonstrating that, while it is effective alone, its use in a cocktail could address the slight differences in phage sensitivity among various P. aeruginosa strains.
Combating the Off-Putting Reality of Bacterial Mutations
The risk of bacterial mutations developing resistance to a single phage is always a real concern. However, when phages are used in combination, the small distinctions and hidden complexities of bacterial defense mechanisms can be overcome more efficiently. This strategy works like a multipronged attack, making it much harder for bacteria to evolve mechanisms to escape all forms of phage assault.
By combining phages with different infection mechanisms, clinicians can create a robust therapeutic regimen that minimizes the chance of developing new drug-resistant strains. Such an approach could eventually reduce the overall load of antibiotics prescribed and lower the cascading effects of antibiotic overuse.
Challenges and the Road Ahead
Even though the benefits of phage therapy are promising, several tricky parts must be sorted out before it can become a routine treatment in veterinary clinics:
- Standardization: Unlike synthetic antibiotics, phages are biological entities that can vary from batch to batch. Establishing consistent standards for phage production and quality control is essential.
- Regulatory Approval: Phage therapy must undergo rigorous regulatory scrutiny. With many regulatory bodies still feeling their way through this new treatment method, getting approvals can be a time-consuming process.
- Phage Resistance: Just as bacteria can develop resistance to antibiotics, there is a risk that they might gradually become less sensitive to phages. This necessitates continuous monitoring and periodic updates to phage formulations.
- Public Acceptance: Both pet owners and veterinarians need to be educated about the benefits and limitations of phage therapy. Overcoming skepticism, fueled by decades of antibiotic-based treatments, is a gradual process.
It is important to note that these challenges are not insurmountable. With continued research, collaboration between researchers, veterinarians, and regulatory bodies, and investment in quality production, phage therapy could soon emerge as an essential, key part of our treatment toolkit for managing recalcitrant bacterial infections.
Integrating Phage Therapy into a Holistic Approach to Health
While phage therapy shows great promise, its best potential is likely to be reached when integrated into a more holistic approach to animal health. This means that phage therapy should not be viewed simply as a replacement for antibiotics, but rather as part of a comprehensive treatment plan that may also include improved hygiene, better nutritional support, and complementary treatments aimed at reducing inflammation and promoting healing.
For instance, the treatment of canine pyoderma might include:
- Phage Therapy: To rapidly target and reduce bacterial counts at the infection site.
- Topical Anti-inflammatory Agents: To soothe irritated skin and reduce redness.
- Nutritional Adjustments: Ensuring that the animal has a balanced diet to support the immune system and skin healing.
This kind of a multifaceted approach not only deals with the immediate bacterial threat but also helps to strengthen the pet’s overall health, reducing the likelihood of future infections. In addition, educating pet owners about preventive measures—such as regular skin care routines and environmental hygiene—can provide critical long-term benefits and lower the overall incidence of such infections.
What Does the Future Hold for Phage Therapy?
Looking forward, the potential for phage therapy in veterinary medicine is immense. As more research studies, like the one involving HJ01, contribute data and refine our understanding of the subtle parts behind phage-bacteria interactions, we can expect a clearer path toward real-world clinical implementations. Several future prospects can be anticipated:
- Expanded Phage Libraries: Building comprehensive libraries of bacteriophages against common and emerging bacterial pathogens will allow for quicker matching of phages to specific infections.
- Personalized Phage Therapy: Just as personalized medicine is making headway in human healthcare, veterinarians may eventually tailor phage treatment regimens to the exact microbial profile of an individual pet’s infection.
- Improved Delivery Systems: Advances in formulations—such as encapsulated phages, topical gels, or sustained-release implants—could further optimize treatment outcomes and ease of use.
- Combination Therapies: Ongoing research into phage-antibiotic super cocktails might offer a dual assault on resistant bacteria, reducing the need for high-dose antibiotic therapies.
These developments promise a future where clinicians are better equipped to tackle the tangled issues that have long plagued the management of bacterial infections. Moreover, by taking a balanced approach that blends innovation with safety and reliability, phage therapy could become a cornerstone of veterinary practice in the coming years.
Conclusion: Charting a New Path for Veterinary Care
The study of phage HJ01 and its therapeutic efficacy in canine pyoderma highlights a promising alternative to conventional antibiotic treatments. By offering a highly specific, rapidly replicating, and overall safe method to combat multidrug-resistant Pseudomonas aeruginosa infections, phage therapy emerges as a bright beacon on the horizon of veterinary medicine.
While many tricky parts remain, including challenges in standardization, regulatory approval, and public acceptance, the research paves the way for a future where these issues can be systematically addressed. A more targeted treatment that spares the natural bacterial flora, reduces recurrence, and ultimately eases the burden of persistent infections is within reach. For pet owners, this could mean fewer frustrating cycles of ineffective treatments and a lower likelihood of adverse effects.
For veterinary practitioners, phage therapy represents not only a therapeutic breakthrough but also a welcome expansion of the treatment toolbox. As we continue to dig into the details of phage biology, explore optimized delivery methods, and integrate these treatments into a holistic care model, there is a strong possibility that our approach to bacterial skin infections will undergo a transformative change.
In essence, phage therapy is not a magic bullet that will solve every problem overnight. Rather, it is a sophisticated, evolving strategy that—in combination with other supportive treatments—could significantly ameliorate the current issues associated with antibiotic resistance. By embracing innovative alternatives like HJ01, we may finally be able to figure a path through the overwhelming maze of antibiotic overuse and microbial resistance, offering a safer, more effective treatment option for our companion animals.
Ultimately, the move toward phage therapy signals an important shift in our understanding of infectious disease management. As clinicians, researchers, and pet owners come together to explore and refine these treatments, the future of veterinary care looks set to benefit from these new and exciting developments. With ongoing research and collaborative efforts, the day when phage therapy becomes a routine, reliable option in the fight against stubborn bacterial infections may not be far off.
It is a fascinating time in veterinary medicine, and the promise of phage therapy provides a glimmer of hope. As we continue to work through the complicated pieces and fine shades of bacterial infections, it is important to keep in mind that such innovative treatments are not only essential but could also represent a safer, more sustainable alternative to the traditional use of antibiotics. In doing so, we are not only ensuring better health outcomes for our pets but also playing a key part in curbing the global threat of antimicrobial resistance.
In conclusion, while further studies and larger clinical trials are needed to fully validate and standardize phage therapy protocols, the evidence thus far is encouraging. The research on phage HJ01 provides a solid experimental foundation upon which future therapeutic strategies can be built. By combining scientific innovation with practical clinical applications, phage therapy holds great promise for easing the complicated intertwined issues of antibiotic resistance in the realm of companion animal wellness.
Originally Post From https://bmcvetres.biomedcentral.com/articles/10.1186/s12917-025-04877-8
Read more about this topic at
Phage Therapy in Veterinary Medicine – PMC
Bacteriophage Therapy in Companion and Farm Animals